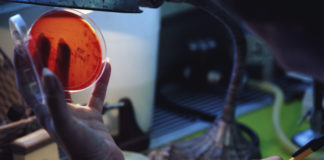
Ceftolozano/tazobactam per infezioni da batteri multiresistenti

Tag: Antibiotico-resistenza
G7 Salute a Milano: accordo per una Salute Globale
Cambiamento climatico, salute della donna, del bambino e dei migranti e antibiotico-resistenza. Ecco l'impegno dichiarato dai delegati G7 per la salute a Milano
Studio sul monitoraggio degli inquinanti emergenti
Integroni per l’analisi dell’inquinamento da antibiotici
Integroni di classe 1 utilizzati come bioindicatori facilitano l'individuazione dell'inquinamento di un ecosistema, compreso quello da antibiotici
Intervento del Presidente AIFA
Uso appropriato degli antibiotici. Melazzini: «È necessario un approccio condiviso e...
L’informazione corretta è il presupposto essenziale
Impegno multidisciplinare per limitare diffusione di patogeni pericolosi